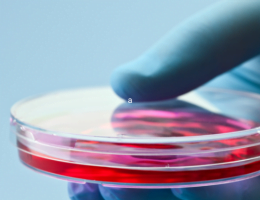

Italijanski raziskovalci v preglednem članku ugotavljajo pozitivne učinke CBD pri avtizmu. Zanimiva …


Italijanski raziskovalci v preglednem članku ugotavljajo pozitivne učinke CBD pri avtizmu. Zanimiva …
Tudi ekipa iz Novega Sada poroča o pozitivnih učinkih terapije …

Študija primerja koncentracije aminokislin v krvi med osebami z avtozmom in …

Raziskava ugotavlja, da uporaba Paracetamola proti bolečinam in vročini med nosečnostjo povečuje rizik …

Individualne terapije in skupinske delavnice za otroke z avtizmom (plavanje, …

Raziskava ugotavlja številne negativne posledice pri otrocih, ki so že v …

Ponovna preiskava oseb z avtizmom, ki so pred dvemi leti sodelovali v …

Autism Research Institute že od davnega leta 1967 deluje na področju …

Prestižna revija Pediatrics je objavila nove podatke o naraščanju incidence …

Študija je TUKAJ